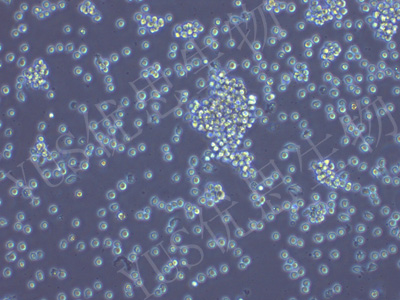

产品中心
产品中心
-

AC16 人心肌细胞(STR鉴定)
货号:YLH173规格: 1*10^6 -

MDA-MB-157 人乳腺癌细胞(STR鉴定)
货号:YLH174规格: 1*10^6 -

RT4 人膀胱移行细胞乳头瘤(STR鉴定)
货号:YLH175规格: 1*10^6 -

HFF-1 人皮肤成纤维细胞(STR鉴定)
货号:YLH176规格: 1*10^6 -

EA.hy926 人脐静脉细胞融合细胞(STR鉴定)
货号:YLH177规格: 1*10^6 -

ES-2 人卵巢透明细胞癌细胞(STR鉴定)
货号:YLH178规格: 1*10^6 -

hTERT-HPNE 人胰腺导管细胞(STR鉴定)
货号:YLH179规格: 1*10^6 -

8305C 人甲状腺癌细胞(未分化)(STR鉴定)
货号:YLH180规格: 1*10^6 -

Hkb20 人肾上皮细胞(STR鉴定)
货号:YLH181规格: 1*10^6 -

MIA-PACA-2 人胰腺癌细胞(STR鉴定)
货号:YLH182规格: 1*10^6 -

KYSE-140 人食管鳞癌细胞(STR鉴定)
货号:YLH183规格: 1*10^6 -
NCI-H716 人结直肠腺癌细胞(STR鉴定)
货号:YLH184规格: 1*10^6
在线咨询
Online consultation

关注微信公众号


